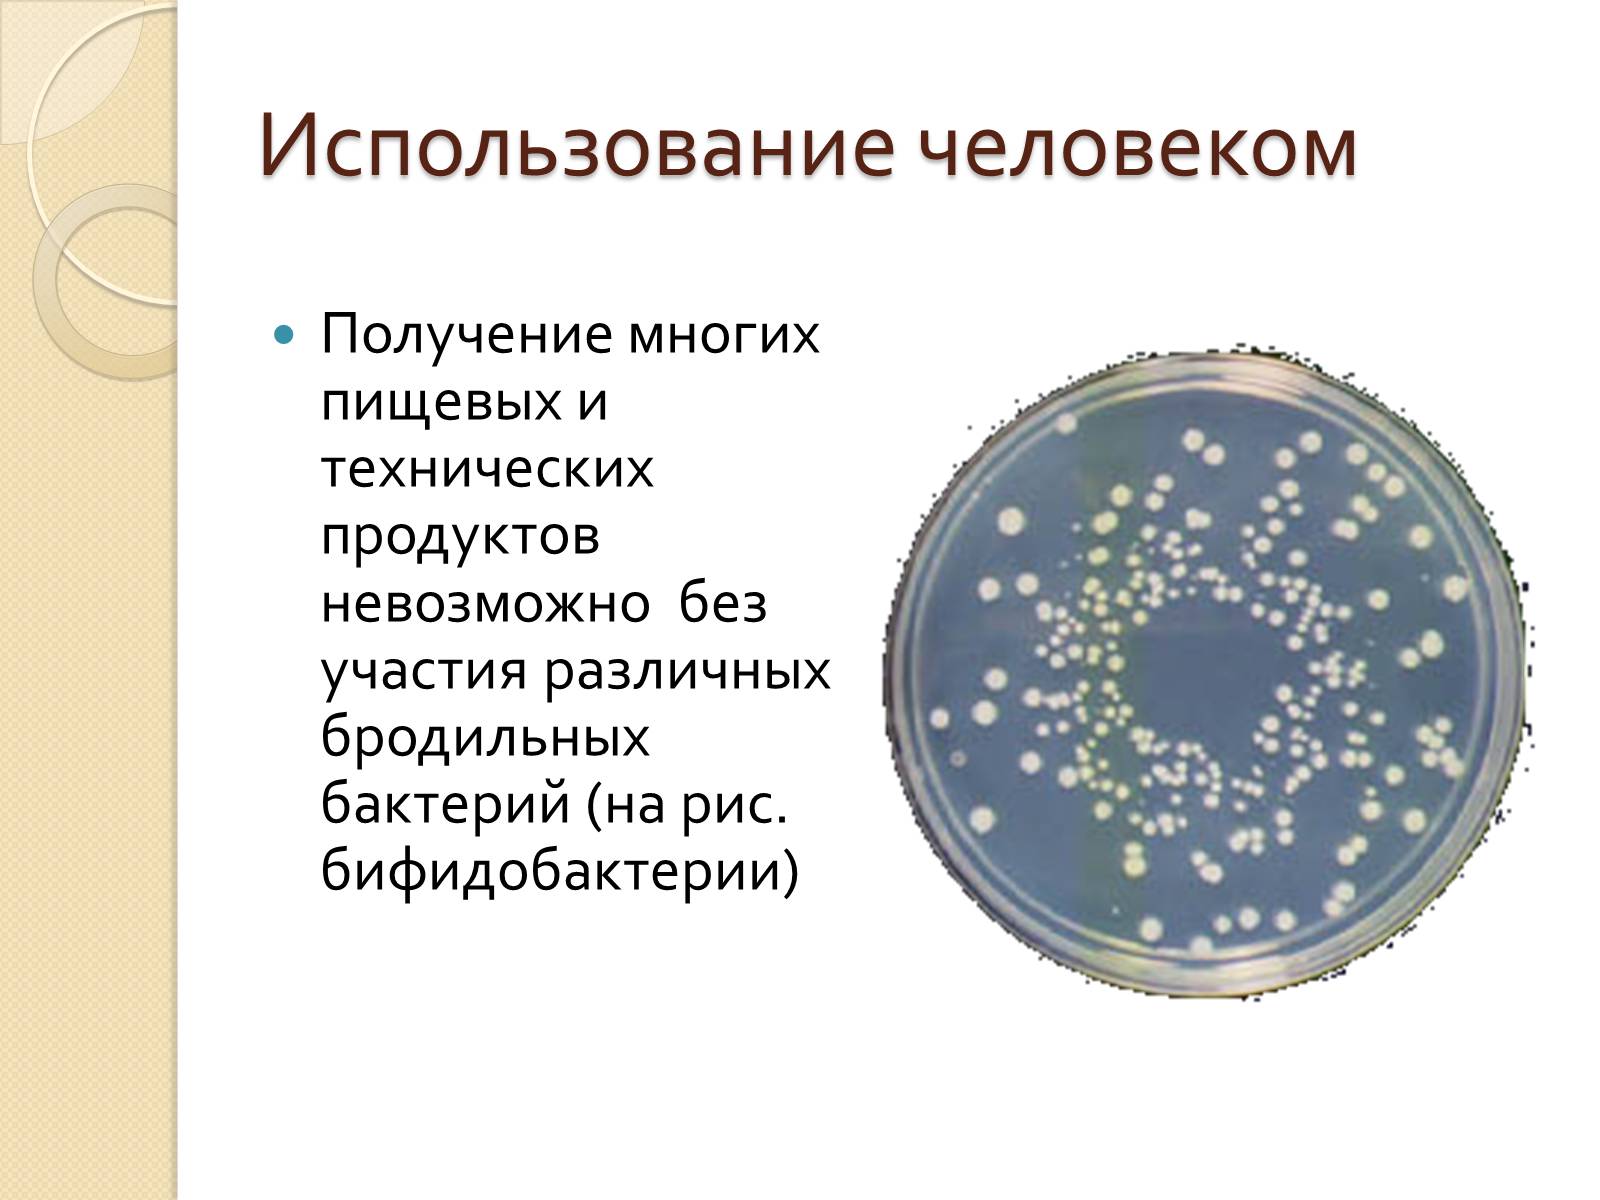

- Головна
- Готові шкільні презентації
- Презентація на тему «Прокариоты» (варіант 3)
Презентація на тему «Прокариоты» (варіант 3)
213
Поділитись підручником в соціальних мережах
Слайд #1
Прокариоты

Слайд #2
Бактерии – «великие могильщики природы»tttttЛуи Пастер.
Эти маленькие организмы создали жизнь на Земле, совершают глобальный круговорот веществ в природе, а также стоят на службе у человека.
Эти маленькие организмы создали жизнь на Земле, совершают глобальный круговорот веществ в природе, а также стоят на службе у человека.

Слайд #3
Свойства
1. Происхождение
2. Среда обитания и распространенность
3. Размеры
4. Форма
5. Строение бактериальной клетки
6. Обмен веществ, отношение к кислороду
7. Питание
8. Размножение
9. Спорообразование
10. Роль в природе
11. Использование человеком
1. Происхождение
2. Среда обитания и распространенность
3. Размеры
4. Форма
5. Строение бактериальной клетки
6. Обмен веществ, отношение к кислороду
7. Питание
8. Размножение
9. Спорообразование
10. Роль в природе
11. Использование человеком

Слайд #4
Происхождение прокариот
Первоначально появились в бескислородной среде 2,5-3 млрд. лет назад в морях
Первоначально появились в бескислородной среде 2,5-3 млрд. лет назад в морях

Слайд #5
Среда обитания прокариот
Атмосфера
Гидросфера
Литосфера
Внутри клеток
Атмосфера
Гидросфера
Литосфера
Внутри клеток

Слайд #6
Размеры
Размеры бактериальных клеток колеблются в пределах от 1 до 10-15 мкм
Размеры бактериальных клеток колеблются в пределах от 1 до 10-15 мкм

Слайд #7
Форма
Кокки
Диплококки
Тетракокки
Кокки
Диплококки
Тетракокки

Слайд #8
Форма
Стрептококки
Стрептококки

Слайд #9
Форма
Сарцины
Стафилококи
Палочки (бациллы)
Сарцины
Стафилококи
Палочки (бациллы)

Слайд #10
Форма
Спириллы
Спирохеты
Вибрионы
Спириллы
Спирохеты
Вибрионы

Слайд #11
Строение бактериальной клетки
На поверхности бактерий часто заметны разного рода жгутики (пилли) и ворсинки (фимбии) – органоиды движения, с помощью которых они передвигаются путем скольжения.
На поверхности бактерий часто заметны разного рода жгутики (пилли) и ворсинки (фимбии) – органоиды движения, с помощью которых они передвигаются путем скольжения.

Слайд #12
Строение бактериальной клетки
1 — клеточная стенка, 2 — наружная цитоплазматическая мембрана, 3 — хромосома (кольцевая молекула ДНК), 4 — впячивание наружной цитоплазматической мембраны, 5 — вакуоли, 6 — мезосома (вырост наружной мембраны), 7 — стопки мембран, в которых осуществляется фотосинтез, 8 — рибосома, 9 — жгутики.
1 — клеточная стенка, 2 — наружная цитоплазматическая мембрана, 3 — хромосома (кольцевая молекула ДНК), 4 — впячивание наружной цитоплазматической мембраны, 5 — вакуоли, 6 — мезосома (вырост наружной мембраны), 7 — стопки мембран, в которых осуществляется фотосинтез, 8 — рибосома, 9 — жгутики.

Слайд #13
Строение бактериальной клетки
Клеточная стенка прокариот жесткая, содержит полисахариды и аминокислоты. Основной упрочняющий компонент – муреин Клеточная стенка многих бактерий сверху покрыта слоем слизи.
Цитоплазма окружена мембраной, отделяющей ее изнутри от клеточной стенки.
Клеточная стенка прокариот жесткая, содержит полисахариды и аминокислоты. Основной упрочняющий компонент – муреин Клеточная стенка многих бактерий сверху покрыта слоем слизи.
Цитоплазма окружена мембраной, отделяющей ее изнутри от клеточной стенки.

Слайд #14
Строение бактериальной клетки
Основная особенность – отсутствие ядра, ограниченного оболочкой. Наследственная информация у бактерий заключена в одной хромосоме.
Рибосомы свободные меньше, чем у эукариотов; на них осуществляется биосинтез белка
Основная особенность – отсутствие ядра, ограниченного оболочкой. Наследственная информация у бактерий заключена в одной хромосоме.
Рибосомы свободные меньше, чем у эукариотов; на них осуществляется биосинтез белка

Слайд #15
Обмен веществ
По отношению к кислороду прокариоты делятся на две группы:
анаэробные (не нуждающиеся в кислороде);
аэробные, (живущие в кислородной среде);
некоторые бактерии могут жить как в бескислородной, так и в кислородной средах
По отношению к кислороду прокариоты делятся на две группы:
анаэробные (не нуждающиеся в кислороде);
аэробные, (живущие в кислородной среде);
некоторые бактерии могут жить как в бескислородной, так и в кислородной средах

Слайд #16
Питание
По способам питания делятся на:
автотрофы - получают энергию за счет фотосинтеза (цианобактерии) и хемосинтеза (железобактерии, азотобактер, пурпурные серобактерии);
гетеротрофы –получают энергию за счет готовых органических веществ. Гетеротрофы, в свою очередь, подразделяются на сапротрофы, паразиты и симбионты.
По способам питания делятся на:
автотрофы - получают энергию за счет фотосинтеза (цианобактерии) и хемосинтеза (железобактерии, азотобактер, пурпурные серобактерии);
гетеротрофы –получают энергию за счет готовых органических веществ. Гетеротрофы, в свою очередь, подразделяются на сапротрофы, паразиты и симбионты.

Слайд #17
Бактерии-паразиты
Паразиты – это бактерии, которые питаются за счет клеток живых организмов, вызывая заболевания (мучнистая роса, виноградная филлоксера, палочка Коха (туберкулезная), столбнячная палочка, дизентерийная палочка, холерный вибрион и др.)
Паразиты – это бактерии, которые питаются за счет клеток живых организмов, вызывая заболевания (мучнистая роса, виноградная филлоксера, палочка Коха (туберкулезная), столбнячная палочка, дизентерийная палочка, холерный вибрион и др.)

Слайд #18
Размножение
У бактерий выделяют два способа размножения: путем деления клетки надвое и половой
У бактерий выделяют два способа размножения: путем деления клетки надвое и половой

Слайд #19
Спорообразование
Многим бактериям свойственно спорообразование. Споры возникают, когда ощущается недостаток в питательных веществах или когда в среде накапливаются продукты обмена, т.е. возникают неблагоприятные условия
Многим бактериям свойственно спорообразование. Споры возникают, когда ощущается недостаток в питательных веществах или когда в среде накапливаются продукты обмена, т.е. возникают неблагоприятные условия

Слайд #20
Роль в природе
А) Бактерии разрушают остатки органического вещества, производят минерализацию.
Б) Бактерии – симбионты (кишечная палочка), поселяясь в пищеварительном тракте у животных, расщепляют целлюлозу до глюкозы, и обеспечивает усвоение этих веществ организмом животных, производят витамины и другие вещества.
В) Азотфиксирующие (клубеньковые) бактерии способствуют усвоению почвенного азота корнями растений.
А) Бактерии разрушают остатки органического вещества, производят минерализацию.
Б) Бактерии – симбионты (кишечная палочка), поселяясь в пищеварительном тракте у животных, расщепляют целлюлозу до глюкозы, и обеспечивает усвоение этих веществ организмом животных, производят витамины и другие вещества.
В) Азотфиксирующие (клубеньковые) бактерии способствуют усвоению почвенного азота корнями растений.

Слайд #21
Использование человеком
Получение многих пищевых и технических продуктов невозможно без участия различных бродильных бактерий (на рис. бифидобактерии)
Получение многих пищевых и технических продуктов невозможно без участия различных бродильных бактерий (на рис. бифидобактерии)
Слайд #22
Отрицательная роль бактерий
Различные виды гнилостных бактерий вызывают порчу пищевых продуктов. Сальмонеллез, ботулизм, холера дизентерия, являются заболеваниями, связанными с употреблением испорченных продуктов.
Коклюш, туберкулез, чума, венерические заболевания, столбняк, воспаление легких и многие другие передаются воздушно – капельным или половым путем.
Различные виды гнилостных бактерий вызывают порчу пищевых продуктов. Сальмонеллез, ботулизм, холера дизентерия, являются заболеваниями, связанными с употреблением испорченных продуктов.
Коклюш, туберкулез, чума, венерические заболевания, столбняк, воспаление легких и многие другие передаются воздушно – капельным или половым путем.
